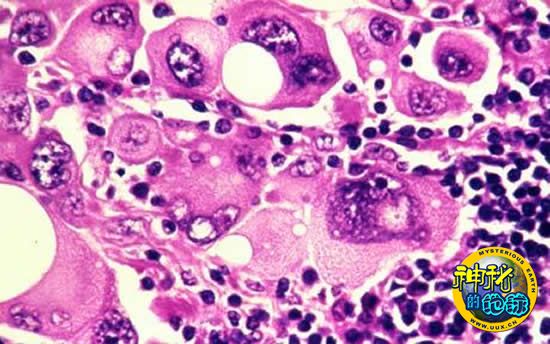

新型抗癌药物可阻断特定基因变异
新型抗癌药物可阻断特定基因变异
据英国《每日电讯报》9月16日(北京时间)报道,美国研究人员研究出了一种药物,可以阻断与恶性黑色素瘤密切相关的B-RAF突变。科学家认为,未来有望研发出药物用以主要攻击与特定肿瘤相关的基因变异。研究发表在9月16日出版的《自然》杂志上。
研究人员表示,新药的问世也预示着制药公司能够根据单个癌症病人的基因情况来提供药物,这些药物将阻止癌症恶化并让目前存在的肿瘤朝良性方向发展。也有科学家称,这种药物的问世可与青霉素的问世相媲美。青霉素作为第一种抗生素,其发现是人类医药史上最重大的发现之一。
多年来,科学家一直试图利用人类基因组计划提供的大量遗传信息来打败癌症,然而,他们在癌症治疗领域取得的进展微乎其微,此项发现应是其中最重要的进展之一。
在最新研究中,美国加州科学家研发出的这种药物能阻断B-RAF基因突变的影响。B-RAF突变在致命性的恶性黑色素瘤病人中最为常见,但也可在其他诸如胸腺癌、结肠癌、子宫癌、乳腺癌和肺癌等癌症患者中发现。
小规模临床试验显示,参与实验的具有B-RAF突变的32名病人中,有24名病人的肿瘤至少减少了30%;并且,另外有两名病人的肿瘤完全消失。
研究人员表示,现在就认为这种药物完全获得了成功还为时过早。该药物也会产生一些副作用,而且,其仅能治疗特定的B-RAF突变。不过,研究已经表明,研发出同样针对特定基因变异(与不同的肿瘤有关)的药物非常有潜力。
目前,已有一家公司正对该药进行测试,以诊断出哪个罹患恶性黑色素瘤的病人拥有B-RAF突变,且可从该药物中受益。
第一个发现B-RAF与恶性黑色素瘤有关的剑桥桑格研究所所长马克·斯特拉顿表示,应该开始从基因的角度来理解癌症形成的根源。维康基金会主席马克·沃尔波特认为,对于癌症研究专家来说,该药物的问世可与人类发现青霉素相媲美。不过,癌症非常复杂,人们还需要对其展开更进一步的研究。
刘霞 科技日报